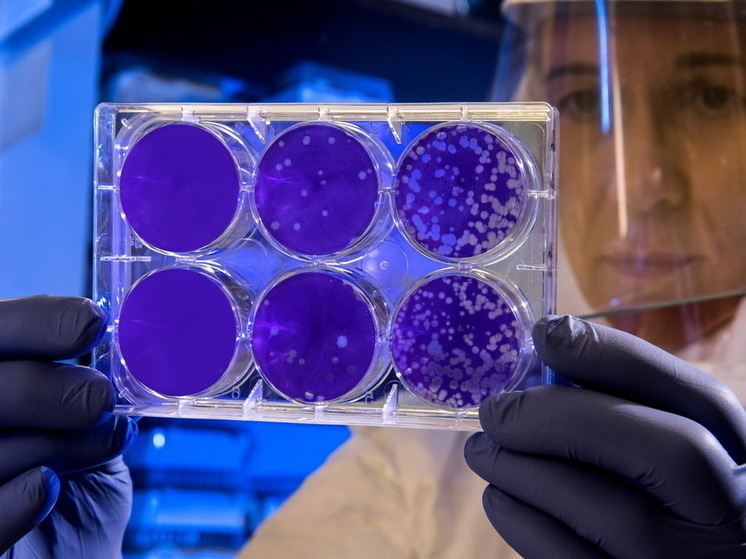
Ученые назвали первую болезнь, которая мучила людей еще миллионы лет назад

Ученые отмечают, что бактерии проказы не существуют вне организма человека. Они существовали более десяти миллионов лет назад и, судя по всему, расселялись по планете вместе с человеком.
При этой болезни страдает кожа и слизистая оболочка верхних дыхательных путей, а также нервы. Без лечения больной со временем теряет человеческий облик.
Проказа существует и сегодня, правда, только в тропических странах.